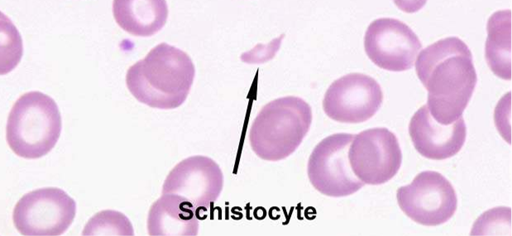

(Ciencias de Joseleg)(Biología)(Introducción y biología
celular)(La
sangre)(Introducción)(Historia)(El
citosol y otros fluidos intracelulares)(Diferentes
tipos de sangre)(Los
colores de la sangre)(Las
funciones de la sangre)(Plasma
sanguíneo y sus componentes)(Propiedades
de la sangre total y su análisis)(Sistema
de grupos sanguíneos)(Glóbulos
rojos o eritrocitos)(Glóbulos
blancos o leucocitos)(Las
plaquetas o trolbocitos)(Hematopoyesis)(Origen
de otros componentes de la sangre)(Referencias
bibliográficas)(Versión
documento word)
También denominadas células rojas o eritrocitos, son el tipo de células más comunes en el torrente sanguíneo y son el principal mecanismo para la distribución de oxígeno a los tejidos, desde el sistema de capilares respiratorios (anclados a las branquias, los alveolos, la piel o cualquier órgano encargado de la respiración externa) hasta los tejidos internos del cuerpo. Los eritrocitos actúan básicamente como bolsas para contener una proteína soluble denominada hemoglobina, esta proteína es básicamente un marco que optimiza la función natural del hierro de oxidarse o reducirse dependiendo de las concentraciones de oxígeno y dióxido de carbono presentes en un medio, es decir, tratamos con una biomolécula cuyo centro activo se basa en una función netamente inorgánica.
Figura 38. Forma de un glóbulo rojo, "arriba" tenemos una vista
lateral que revela la forma aplanada en forma de moneda con una región centran
deprimida en forma de dona. "Abajo" tenemos la vista al microscópio
con un borde mucho más marcado y un centro claro (YouTube)(YouTube).
Cuando el hierro pasa del estado ferroso al estado férrico
adquiere una coloración marrón-rojiza, lo que, al ser optimizado por la
proteína alrededor de él, genera una coloración roja más intensa, en otras
palabras, es el hierro presente en el centro activo de la hemoglobina quien es
responsable del color rojo de la sangre. Los eritrocitos morfológicamente se
distinguen de otras células al poseer una forma de disco aplanado bicóncavo, al
microscopio se asemejan a una dona o a un roscón. Los eritrocitos de los mamíferos carecen de
núcleos, lo cual es una característica más bien única, ya que los eritrocitos
de los demás vertebrados si poseen núcleo.
En los seres humanos, la vida media de un eritrocito funcional dura alrededor de 100 a 120 días y son reciclados por una combinación del sistema de capilares y los leucocitos macrófagos.
Como lo dijimos en la introducción, los eritrocitos son
células aplanadas bicóncavas, similar a una dona, su diámetro es de 7 µm con un
grosor máximo de 2,5 µm. ¿Por qué no son esféricos?, recordemos que la esfera
es la forma que posee un mayor volumen posible, por lo que los eritrocitos
esféricos podrían teóricamente cargar una mayor cantidad de hemoglobina y por
lo tanto más oxígeno, ¿cierto? La respuesta a este asunto radica en la
velocidad, al incrementar el volumen, el área disminuye y por consiguiente la
velocidad de intercambio de gases, un eritrocito esférico se tardaría más
tiempo en intercambiar gases metabólicos y en suma, haría de la respiración un
proceso más lento e incómodo. Al aplanar los eritrocitos, la superficie o área
de estos aumenta, incrementando la velocidad de intercambio de gases, cada
eritrocito carga menos oxígeno, pero intercambia gases a una mayor velocidad.
Los eritrocitos también juegan un papel importante en
mantener el equilibrio de acidez del cuerpo. Cuando el dióxido de carbono se
mezcla con el agua del plasma reacciona de manera típica produciendo ácido
carbónico molecular, el cual subsecuentemente reacciona con más agua para
disociarse, generando un equilibrio químico entre la forma molecular, el ion
acetato y el ion hidronio. Cuando se libera ion hidronio a una solución esta
aumenta su pH (potencian de iones hidronio) y por lo tanto se hace más acida.
La acidez es un factor de vital cuidado para los sistemas bilógicos, ya que las
proteínas se ven afectadas en sus funciones si la acidez de su medio cambia. La
hemoglobina funciona como una solución buffer cuando está disuelta en el
plasma, manteniendo una concentración constante de iones hidrogeniones.
La alteración en la forma de los eritrocitos, ya sea en composición o en la membrana puede conllevar a alteraciones en su forma microscópica, los cuales proveen información importante para el diagnóstico de patologías. La membrana de los eritrocitos está unida a un esqueleto fibroso de proteínas intracelulares. La organización estructural le otorga a la célula estabilidad así como flexibilidad. Los eritrocitos normales poseen una forma de disco aplanado con el centro hundido de forma tal que al microscopio parecen anillos gruesos, roscones o donas rosadas.
Figura 39. Glóbulos rojos.
La alteración morfológica de los eritrocitos puede diferenciarse
en las siguientes categorías: Cambios de tamaño y forma; Cambios de
pigmentación; Inmadurez; Inclusiones y cuerpos extraños.
La variación notable en el tamaño o la forma de las células se denomina anisocitosis (forma diferente). Los eritrocitos más grandes de lo normal son designados con el termino macrocitos; mientras que los más pequeños microcitos.
Figura 40. En las anisocitocis los eritrocitos presentan tamaños diversos.
Figura 41. La poiquilocitosis se caracteriza por una irregularidad en las formas, los equinocitos o células de Burr, son eritrocitos con forma espinosa generados por la alteración del plasma alrededor de los eritrocitos debido a la pérdida de agua.
Figura 42. Existe otra manera en que los eritrocitos pueden experimentar
cambios de forma, cuando pasan a través de vasos sanguíneos capilares anormales
(muy delgados) los eritrocitos alteran su forma al pasar de manera permanente,
quedando deformes, a estos se los denomina esquistocitos.
El contenido anormal de hemoglobina en los eritrocitos puede conllevar a una coloración anormal cuando se fijan con tinciones durante los frotis al microscopio .
Figura 43. Eritrocitos normocrómicos "color normal" a la izquierda
y eritrocitos hipocrómicos "bajos de color" a la derecha.
Los eritrocitos normales aparecen como roscones rojos-anaranjados-morados-rosados dependiendo del colorante utilizado, la zona central pareciera inexistente debido a la forma bicóncava, a esta coloración se la denomina normocrómica. Los eritrocitos hipocrómicos se manifiestan casi decoloreados, solo con un anillo muy tenue de coloración en la periferia. Los dianocitos son otra alteración en forma y color, ocurre cuando el centro del eritrocito que normalmente debe aparecer decoloreado aparece con un circulo como si fuera una diana de tiro al blanco.
Figura 44. Dianocitos.
Otra variación patológica en la coloración de una célula roja es en realidad una alteración en su forma. Los eritrocitos con forma esférica se presentan totalmente coloreados al microscopio por lo cual se los denomina esferocitos.
Figura 45. Esferocitos.
Como dijimos antes, los eritrocitos normales parecen
roscones/donas/anillos al microscopio, con la zona central aparentemente vacía,
sin embargo, en algunas ocasiones los eritrocitos aparecen “aparentemente llenos”
esto se debe a que presentan una forma esférica y por lo tanto se los denomina
esferocitos.
Los eritrocitos normales y maduros en los mamíferos como los seres humanos carecen de núcleos, y por lo tanto la presencia de glóbulos rojos con núcleos en la sangre circulante posee un significado diagnóstico.
Figura 46. Normoblasto.
Un tipo específico de glóbulo rojo nucleado se puede encontrar en ciertos tipos de anemias llamado normoblasto “Figura 46. Normoblasto.”, se presenta cuando hay una gran pérdida de sangre y la persona empieza a producir tanto que no da abasto, la aparición de los normoblastos es una mala señal que antecede a la muerte en varias horas. Otro tipo de eritrocito nucleado es el megaloblasto “Figura 47” puede detectarse en la sangre circulante cuando hay presencia de anemia por deficiencia de ácido fólico.
Figura 47. Megaloblasto, es una
célula con un enorme núcleo púrpura.
Los retioculocitos “Figura 48” son células inmaduras que han perdido sus núcleos, pero que aún conservan algo del material nuclear el cual puede ser visible mediante una coloración especial. El porcentaje de reticulocitos es un indicador del nivel de eritropoyesis (formación de eritrocitos) en el tuétano. Por ejemplo, si el paciente esta anémico y el tuétano esta funcionando adecuadamente el nivel de reticulocitos (globulos rojos muy jóvenes) debe ser alto.
Figura 48. Reticulocitos.
Existe una gran abundancia de otras anormalidades en los eritrocitos que pueden ser resultado de hemoglobinopatías (drepanocitos, falciformes como en la imagen siguiente) enfermedades hepáticas (estomatocitos), hematopoyesis fuera del tuétano (dacriocitos).
Figura 49. Eritrocitos falciformes.
Las células también pueden presentar “artefactos” que son inclusiones de proteínas resultados de la anormalidad en la hemoglobina, envenenamiento por plomo o por una eritropoyesis anormal. Los glóbulos rojos también pueden presentar inclusiones anormales debido al ingreso de cuerpos extraños, como la infección por parásitos intracelulares, tales como la malaria o la babesia.
Figura 50. Alteraciones morfológicas
de un eritrocito infectado por el parásito causante de la malaria.

No hay comentarios:
Publicar un comentario